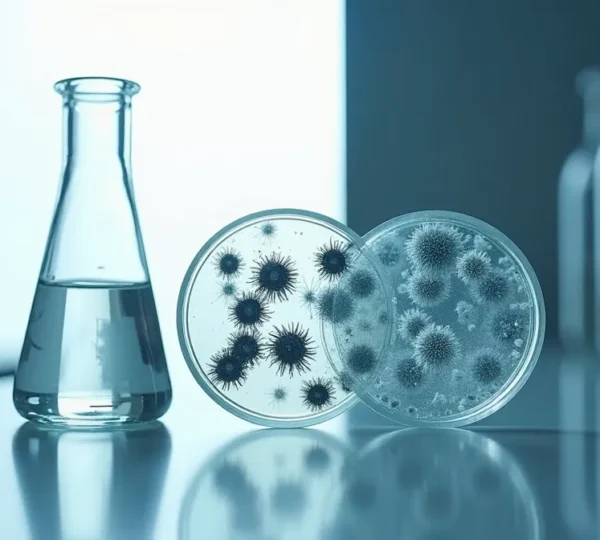

Die Haut ist mit etwa zwei Quadratmetern unser größtes Organ und gleichzeitig eine faszinierende Schutzbarriere, die täglich Höchstleistungen vollbringt. Doch gerade weil sie so vielen Einflüssen ausgesetzt ist – von UV-Strahlung über Umweltverschmutzung bis hin zu hormonellen Schwankungen – braucht sie gezielte Unterstützung. Hautpflege ist dabei weit mehr als ein kosmetisches Ritual: Sie ist eine Investition in die Gesundheit und Widerstandsfähigkeit unserer Haut.
Gleichzeitig herrscht in der Welt der Hautpflege eine enorme Informationsflut. Hunderte Produkte, widersprüchliche Ratschläge und komplizierte Fachbegriffe machen es schwer, den Überblick zu behalten. Dieser Artikel bietet eine fundierte Orientierung: Von den biologischen Grundlagen über die wichtigsten Wirkstoffe bis hin zum Aufbau einer individuellen Pflegeroutine – hier erfahren Sie, worauf es wirklich ankommt.
Bevor man sich mit Produkten und Wirkstoffen beschäftigt, lohnt sich ein Blick auf die Biologie der Haut selbst. Nur wer versteht, wie die Haut funktioniert, kann sie auch optimal pflegen.
Die Hautoberfläche ist von einem dünnen Film aus Talg, Schweiß und natürlichen Feuchthaltefaktoren bedeckt – dem sogenannten Säureschutzmantel. Dieser hat idealerweise einen pH-Wert zwischen 4,5 und 5,5, also im leicht sauren Bereich. Dieser saure pH-Wert ist keineswegs zufällig: Er schützt vor schädlichen Bakterien, reguliert Enzyme und hält die Hautbarriere intakt.
Viele herkömmliche Seifen haben jedoch einen alkalischen pH-Wert von 8 oder höher. Das Ergebnis: Der Säureschutzmantel wird gestört, die Haut fühlt sich nach der Reinigung gespannt an und braucht mehrere Stunden, um ihren natürlichen pH-Wert wiederherzustellen. Daher sollten Reinigungsprodukte idealerweise pH-neutral oder leicht sauer formuliert sein.
Auf unserer Haut leben Milliarden von Mikroorganismen – Bakterien, Pilze und Viren –, die zusammen das Hautmikrobiom bilden. Diese mikrobielle Gemeinschaft ist nicht nur harmlos, sondern sogar essenziell für eine gesunde Haut. Ein ausgewogenes Mikrobiom schützt vor Krankheitserregern, reguliert Entzündungen und stärkt die Barrierefunktion.
Aggressive Reinigung, übermäßiger Einsatz von Desinfektionsmitteln oder bestimmte Konservierungsstoffe können dieses empfindliche Gleichgewicht jedoch stören. Die Folge können Hautprobleme wie Trockenheit, Rötungen oder sogar Akne sein. Eine hautfreundliche Pflege respektiert und unterstützt das Mikrobiom, statt es zu bekämpfen.
Der Hauttyp ist genetisch bedingt und bleibt ein Leben lang relativ konstant: Man unterscheidet zwischen normaler, trockener, fettiger und Mischhaut. Der Hautzustand hingegen ist variabel und wird durch äußere Faktoren beeinflusst – etwa durch das Klima, Stress, Hormone oder falsche Pflege.
Eine fettige Haut kann beispielsweise dehydriert sein, wenn ihr Wasser fehlt, obwohl sie genug Talg produziert. Diese Unterscheidung ist entscheidend für die Produktwahl: Während der Hauttyp die Grundlage bildet, müssen aktuelle Hautzustände gezielt adressiert werden.
Eine gründliche, aber schonende Reinigung ist der erste und wichtigste Schritt jeder Hautpflegeroutine. Sie entfernt Schmutz, überschüssigen Talg, Make-up und Umweltpartikel – und bereitet die Haut optimal auf nachfolgende Pflegeprodukte vor.
Die Frage nach der optimalen Reinigungshäufigkeit lässt sich nicht pauschal beantworten. Grundsätzlich gilt: Zweimal täglich – morgens und abends – ist für die meisten Hauttypen ideal. Morgens entfernt man Talg und Schweiß, die über Nacht produziert wurden; abends werden Make-up, Sonnenschutz und Umweltverschmutzung beseitigt.
Wichtig ist jedoch die Art der Reinigung. Mechanische Reinigung durch Peelingpartikel, Bürsten oder raue Handtücher kann die Hautbarriere schädigen und Mikroverletzungen verursachen. Besser sind sanfte Reinigungsgele, Öle oder Mizellenwasser, die gründlich reinigen, ohne zu reizen. Das Gesicht sollte mit den Fingerspitzen in kreisenden Bewegungen gereinigt und mit einem weichen Handtuch vorsichtig abgetupft – nicht gerieben – werden.
Ein oft übersehener Faktor ist die Wasserqualität. In Regionen mit hartem Wasser können Kalkablagerungen die Haut austrocknen und den pH-Wert verschieben. Wer in Gebieten mit besonders hartem Wasser lebt, kann auf Mizellenwasser als rinse-off-freie Alternative zurückgreifen oder nach der Reinigung ein Gesichtswasser mit leicht saurer Formulierung verwenden, um den pH-Wert zu normalisieren.
Gut hydrierte Haut ist widerstandsfähig, geschmeidig und strahlt von innen. Doch Feuchtigkeit ist mehr als nur ein kosmetischer Aspekt – sie ist essenziell für alle Zellfunktionen.
Ständig verdunstet Wasser aus den tieferen Hautschichten durch die oberste Hornschicht nach außen – ein Prozess, der als transepidermaler Wasserverlust (TEWL) bezeichnet wird. Eine intakte Hautbarriere minimiert diesen Verlust und hält die Feuchtigkeit in der Haut. Ist die Barriere jedoch geschädigt – etwa durch übermäßiges Peeling, aggressive Reinigung oder extreme Witterungsbedingungen –, steigt der TEWL drastisch an. Die Haut wird trocken, schuppig und anfällig für Reizungen.
Moderne Feuchtigkeitspflege basiert auf zwei komplementären Strategien:
Die Kunst liegt in der richtigen Kombination: Feuchthaltemittel ohne Okklusiva können die Haut paradoxerweise austrocknen, wenn die Umgebungsluft sehr trocken ist. Umgekehrt wirken reine Okklusiva auf dehydrierter Haut wie ein Deckel auf einem leeren Topf. Eine ausgewogene Formulierung vereint beide Ansätze.
Ceramide sind lipidähnliche Moleküle, die etwa 50 Prozent der Hautbarriere ausmachen. Sie fungieren wie Mörtel zwischen den Hautzellen und halten die Barriere dicht und stabil. Bei geschädigter Hautbarriere, etwa nach zu intensivem Peeling oder bei Erkrankungen wie Neurodermitis, ist der Ceramid-Gehalt oft reduziert. Pflegeprodukte mit Ceramiden können helfen, die Barriere zu reparieren und die Haut langfristig zu stärken.
Wirkstoffe sind die aktiven Komponenten in Hautpflegeprodukten, die spezifische Hautprobleme adressieren. Doch nicht jeder Wirkstoff ist für jeden geeignet – und die richtige Anwendung ist entscheidend.
Die Wirksamkeit eines Inhaltsstoffs hängt nicht nur von seiner bloßen Anwesenheit in der Formulierung ab, sondern vor allem von seiner Konzentration und seiner Fähigkeit, in die Haut einzudringen. Das Molekulargewicht spielt dabei eine zentrale Rolle: Kleine Moleküle wie Retinol oder Vitamin C können tiefer in die Haut eindringen, während große Moleküle wie hochmolekulare Hyaluronsäure hauptsächlich an der Oberfläche wirken.
Genau deshalb gibt es beispielsweise Hyaluronsäure in verschiedenen Molekülgrößen: Niedermolekulare Varianten dringen tiefer ein und polstern von innen auf, während hochmolekulare Hyaluronsäure einen feuchtigkeitsbindenden Film auf der Hautoberfläche bildet.
Die Kombination verschiedener Wirkstoffe kann synergistische Effekte erzielen – oder zu Hautreizungen führen. Einige Faustregeln:
Retinoide – Abkömmlinge von Vitamin A – gelten als die am besten erforschten Anti-Aging-Wirkstoffe. Sie beschleunigen die Zellerneuerung, fördern die Kollagenproduktion und verblassen Pigmentflecken. Doch sie können auch Reizungen, Rötungen und Schuppungen verursachen, besonders in der Eingewöhnungsphase.
Ein sanfter Einstieg ist entscheidend: Beginnen Sie mit einer niedrigen Konzentration (0,25-0,3 Prozent Retinol) und verwenden Sie das Produkt zunächst nur zweimal pro Woche abends. Steigern Sie die Häufigkeit langsam über mehrere Wochen. Eine begleitende, reichhaltige Feuchtigkeitspflege und konsequenter Sonnenschutz sind unverzichtbar, da Retinoide die Lichtempfindlichkeit erhöhen.
Wenn es einen einzigen Wirkstoff gibt, der nachweislich vorzeitige Hautalterung verhindert, dann ist es Sonnenschutz. Etwa 80 Prozent der sichtbaren Hautalterung werden durch UV-Strahlung verursacht – ein Prozess, der als Photoaging bezeichnet wird.
UV-Strahlung unterteilt sich in zwei relevante Typen:
Ein effektiver Sonnenschutz muss daher Breitbandschutz bieten, also sowohl UVA als auch UVB abdecken. Chemische Filter absorbieren UV-Strahlung und wandeln sie in Wärme um, während mineralische Filter wie Zinkoxid und Titandioxid die Strahlen reflektieren. Beide haben Vor- und Nachteile; entscheidend ist die regelmäßige und ausreichende Anwendung.
Der Lichtschutzfaktor (LSF) gibt an, wie viel länger man sich theoretisch in der Sonne aufhalten kann, ohne einen Sonnenbrand zu bekommen. Ein LSF 30 bedeutet beispielsweise eine 30-fache Verlängerung der Eigenschutzzeit. Doch in der Praxis wird selten die empfohlene Menge von 2 mg pro cm² Haut aufgetragen – für das Gesicht entspricht das etwa einem knappen Teelöffel.
Die meisten Menschen verwenden nur ein Viertel dieser Menge, wodurch der reale Schutz drastisch sinkt. Ein LSF 50 wird bei unzureichender Anwendung schnell zu einem LSF 15. Daher gilt: Lieber zu viel als zu wenig auftragen und alle zwei Stunden nachcremen, besonders nach dem Schwimmen oder Schwitzen.
Von gelegentlichen Unreinheiten bis zu chronischen Hauterkrankungen – die richtige Pflege kann den Unterschied machen. Doch zunächst muss man verstehen, was genau die Ursache ist.
Nicht jeder Pickel ist Akne. Akne ist eine chronische Erkrankung, die durch eine Kombination aus übermäßiger Talgproduktion, verstopften Poren, bakterieller Besiedlung und Entzündung entsteht. Unreinheiten hingegen sind sporadische Hautunreinheiten, die durch hormonelle Schwankungen, Stress oder falsche Pflege ausgelöst werden.
Mitesser entstehen, wenn Talg und abgestorbene Hautzellen die Poren verstopfen. Oxidiert die Oberfläche an der Luft, entsteht ein schwarzer Mitesser (Komedo). Die Versuchung, diese mechanisch auszudrücken, ist groß – doch dies kann zu Entzündungen, Narben und einer weiteren Ausbreitung von Bakterien führen. Besser sind Salicylsäure-basierte Peelings, die die Poren von innen reinigen, oder professionelle Ausreinigungen.
Viele Frauen beobachten, dass sich ihre Haut im Verlauf des Menstruationszyklus verändert. In der zweiten Zyklushälfte, wenn der Progesteronspiegel steigt, produziert die Haut mehr Talg. Dies erklärt, warum Unreinheiten oft kurz vor der Periode auftreten.
Eine zyklusabhängige Pflege passt die Routine an diese Schwankungen an: In der ersten Zyklushälfte liegt der Fokus auf Aufhellung und Regeneration, in der zweiten auf porenverfeinerenden und talgrегулierenden Wirkstoffen wie Niacinamid oder Salicylsäure.
Chronische Hauterkrankungen wie Rosacea (gekennzeichnet durch Rötungen, sichtbare Äderchen und Entzündungen) oder Neurodermitis (mit starkem Juckreiz und Ekzemen) erfordern eine besonders behutsame Pflege. Aggressive Wirkstoffe, Duftstoffe oder auch nur zu viele Produkte können Schübe auslösen.
Bei beiden Erkrankungen steht die Stärkung der Hautbarriere im Vordergrund: Milde, parfümfreie Produkte mit beruhigenden Inhaltsstoffen wie Centella Asiatica, Panthenol oder Azelainsäure können helfen. Zudem sollten bekannte Trigger wie extreme Temperaturen, scharfes Essen oder Alkohol gemieden werden. Eine enge Abstimmung mit Dermatologen ist unerlässlich, besonders bei medikamentösen Therapien.
Dunkle Flecken und ungleichmäßige Pigmentierung können verschiedene Ursachen haben: UV-Strahlung, hormonelle Veränderungen (etwa während der Schwangerschaft), Entzündungen nach Akne oder das natürliche Altern. Melasma ist eine besonders hartnäckige Form der Hyperpigmentierung, die oft symmetrisch im Gesicht auftritt und hormonell bedingt ist.
Die Behandlung erfordert Geduld und einen mehrgleisigen Ansatz: Konsequenter Sonnenschutz ist die Basis, da UV-Strahlung die Pigmentbildung verstärkt. Wirkstoffe wie Vitamin C, Niacinamid, Azelainsäure oder Tranexamsäure können Pigmentflecken aufhellen. Wichtig ist die Kontinuität: Ergebnisse zeigen sich oft erst nach mehreren Monaten.
Eine effektive Hautpflegeroutine ist kein starres Schema, sondern ein individuell angepasstes System, das sich an Ihren Bedürfnissen, Ihrem Lebensstil und den Jahreszeiten orientiert.
Mehr Produkte bedeuten nicht automatisch bessere Haut. Im Gegenteil: Überpflege ist ein weit verbreitetes Phänomen. Zu viele Wirkstoffe, zu häufiges Peeling oder zu reichhaltige Cremes für den eigenen Hauttyp können die Hautbarriere schwächen und zu Irritationen, Unreinheiten oder Empfindlichkeit führen.
Das Konzept der minimalistischen Pflege setzt auf wenige, aber hochwertige Produkte, die optimal aufeinander abgestimmt sind. Eine Basisroutine besteht aus vier Schritten: Reinigung, Feuchtigkeitspflege, Sonnenschutz (morgens) und gegebenenfalls ein gezieltes Serum mit Wirkstoffen. Alles darüber hinaus ist optional.
Die Bedürfnisse der Haut ändern sich mit den Jahreszeiten. Im Winter, wenn die Luft kalt und trocken ist, braucht die Haut reichhaltigere Texturen und mehr Okklusiva, um den erhöhten Feuchtigkeitsverlust auszugleichen. Im Sommer hingegen sind leichtere Formulierungen angenehmer und ausreichend.
Auch die Wirkstoffauswahl kann saisonal variieren: Intensive Retinoid-Kuren oder Säure-Peelings sind im Herbst und Winter oft besser verträglich, wenn die UV-Belastung geringer ist. Im Sommer steht der Sonnenschutz im Vordergrund.
Die Haut braucht Zeit, um auf neue Produkte oder Wirkstoffe zu reagieren. Der Zellerneuerungszyklus dauert etwa 28 Tage – bei reifer Haut sogar bis zu 40 Tage. Wer jede Woche neue Produkte ausprobiert, wird keine verlässlichen Ergebnisse sehen und riskiert, die Haut zu überfordern.
Geben Sie einer neuen Routine mindestens 6-8 Wochen Zeit, bevor Sie deren Wirksamkeit beurteilen. Die einzige Ausnahme: Treten Anzeichen von Unverträglichkeit wie starke Rötungen, Brennen oder Juckreiz auf, sollten Sie das Produkt sofort absetzen.
Der Markt für Hautpflegeprodukte ist unüberschaubar. Vom Discounter bis zur Luxusmarke, von Clean Beauty bis zur Apothekenkosmetik – wie findet man die richtigen Produkte?
Viele Verbraucher gehen davon aus, dass Produkte aus der Apotheke grundsätzlich besser sind. Tatsächlich gibt es Unterschiede: Apothekenkosmetik wird oft strenger geprüft, enthält höhere Wirkstoffkonzentrationen und verzichtet häufiger auf problematische Inhaltsstoffe wie Duftstoffe. Zudem bieten Apotheken oft Beratung durch pharmazeutisches Fachpersonal.
Doch auch Drogerieprodukte können hochwertig sein – und umgekehrt garantiert ein hoher Preis nicht automatisch Wirksamkeit. Entscheidend ist, die Inhaltsstoffliste lesen zu können und die eigenen Hautbedürfnisse zu kennen. Wirkstoffe wie Niacinamid, Panthenol oder Ceramide finden sich in allen Preisklassen.
Die INCI-Liste (International Nomenclature of Cosmetic Ingredients) folgt einem klaren Prinzip: Inhaltsstoffe sind nach absteigender Konzentration aufgeführt. Was an erster Stelle steht, ist am meisten enthalten – meist ist das Wasser (Aqua).
Einige wichtige Begriffe:
Komplizierte chemische Bezeichnungen sind nicht per se schädlich – oft verbergen sich dahinter sogar natürliche Inhaltsstoffe. Umgekehrt sind nicht alle „natürlichen“ Stoffe harmlos: Ätherische Öle etwa können starke Allergene sein.
Hautreaktionen auf Kosmetik sind häufig. Die häufigsten Allergene sind Duftstoffe, Konservierungsstoffe (besonders Parabene und Formaldehyd-Abspalter), bestimmte UV-Filter und ätherische Öle. Bei empfindlicher Haut sollten diese Inhaltsstoffe gemieden werden.
Vor der Anwendung eines neuen Produkts empfiehlt sich ein Patch-Test: Tragen Sie eine kleine Menge des Produkts auf die Innenseite des Unterarms oder hinter das Ohr auf und beobachten Sie die Stelle 24-48 Stunden lang. Treten Rötungen, Juckreiz oder Schwellungen auf, sollten Sie das Produkt nicht im Gesicht verwenden.
Der Trend zu „Clean Beauty“ verspricht Produkte frei von angeblich schädlichen Chemikalien. Doch die Realität ist komplexer: Viele auf „schwarzen Listen“ stehende Inhaltsstoffe sind in den zugelassenen Konzentrationen unbedenklich, während manche natürlichen Ersatzstoffe reizender oder weniger effektiv sind.
Ein kritischer Punkt sind Konservierungsstoffe. Sie verhindern, dass sich in Cremes und Seren Bakterien und Schimmelpilze vermehren – ein wichtiger Sicherheitsaspekt. Produkte ohne Konservierungsstoffe haben eine sehr kurze Haltbarkeit und müssen oft gekühlt gelagert werden. Die Alternative sind luftdichte Verpackungen oder wasserfreie Formulierungen.
„Clean“ ist kein geschützter Begriff und sagt nichts über die tatsächliche Wirksamkeit oder Verträglichkeit aus. Wichtiger als Labels ist ein kritischer Blick auf die Inhaltsstoffe und die eigenen Hautbedürfnisse.
Hautpflege ist keine Einheitslösung, sondern eine individuelle Reise. Die Grundlagen – Reinigung, Feuchtigkeit, Sonnenschutz – bilden das Fundament, auf dem Sie mit gezielten Wirkstoffen und einer durchdachten Routine aufbauen können. Hören Sie auf Ihre Haut, geben Sie Veränderungen Zeit und scheuen Sie sich nicht, bei hartnäckigen Problemen dermatologischen Rat einzuholen. Gesunde Haut ist das Ergebnis von Wissen, Geduld und der richtigen Pflege zur richtigen Zeit.
Entgegen der landläufigen Meinung ist nicht das Paraben in Ihrer Creme die größte Bedrohung, sondern die unkonservierte Creme selbst. Das mikrobielle Risiko durch Keime in schlecht konservierten Produkten ist eine akute Gefahr für die Hautgesundheit. Voreilig verteufelte Inhaltsstoffe werden oft…
Weiter Lesen
Zusammenfassend: Die meisten Duftstoffallergien werden durch eine Liste von 82 gesetzlich geregelten Substanzen ausgelöst, die weit über den Begriff „Parfüm“ hinausgehen. Die Kennzeichnung „hypoallergen“ ist kein rechtlicher Garant für Sicherheit; verlässliche Siegel wie ECARF bieten eine bessere Orientierung. Das Risiko…
Weiter Lesen
Contrairement à l’idée reçue que „naturel“ rime avec „doux“, la puissance des huiles essentielles réside dans leur complexité biochimique. Ce sont précisément leurs molécules actives, sources de bienfaits, qui peuvent se comporter en puissants irritants ou allergènes. Cet article décrypte…
Weiter Lesen
En résumé : Votre peau sous isotrétinoïne n’est pas seulement „sèche“ : sa barrière protectrice est compromise, ce qui exige une stratégie de compensation et non une simple hydratation. Évitez absolument les déclencheurs (alcool, épices, chaleur) et tous les produits…
Weiter Lesen
L’acné adulte n’est pas un retour à l’adolescence, mais le signal d’un déséquilibre de votre écosystème cutané-hormonal. Elle est principalement inflammatoire et cyclique, dictée par vos hormones et votre niveau de stress. Les solutions de surface sont inefficaces sans une…
Weiter Lesen
Si votre peau brûle au contact de n’importe quel produit, c’est le signe que sa barrière protectrice est rompue. La solution n’est pas d’ajouter une crème „miracle“, mais de soustraire les agressions pour permettre à la peau de se réparer…
Weiter Lesen
Entgegen der landläufigen Meinung ist nicht die Reichhaltigkeit einer Creme der Hauptgrund für verstopfte Poren, sondern ihre unsichtbare Struktur und Wechselwirkung mit der Haut. Ungeeignete Emulgatoren in leichten Texturen können die Hautbarriere schwächen und zu Problemen führen. Die Verpackung ist…
Weiter Lesen
Der größte Fehler in der Hautpflege? Zu glauben, Tag- und Nachtcreme seien nur eine Marketing-Erfindung. In Wahrheit arbeitet Ihre Haut nach einer strengen inneren Uhr, und die Synchronisation Ihrer Produkte mit diesem Rhythmus ist der Schlüssel zu sichtbaren Ergebnissen. Tagsüber…
Weiter Lesen
Hartnäckige Pigmentflecken sind kein reines Oberflächenproblem, sondern das Ergebnis eines tiefen „Pigmentgedächtnisses“ der Haut, das ständig reaktiviert wird. Trigger wie Hormone und unsichtbare UVA-Strahlung (auch durch Glas) reaktivieren Flecken immer wieder, selbst bei Verwendung von Sonnencreme. Die Wirksamkeit von Vitamin…
Weiter Lesen
Teure Cremes allein bekämpfen keine Falten, wenn die Ursache tiefer liegt: im Stoffwechsel. Das „Zuckergesicht“ ist das Ergebnis eines biochemischen Stresses, der von innen kommt. Glykation, die „Verzuckerung“ der Kollagen-Matrix, ist der Haupttreiber für starre, tiefe Falten. Faktoren wie Schlaf,…
Weiter Lesen